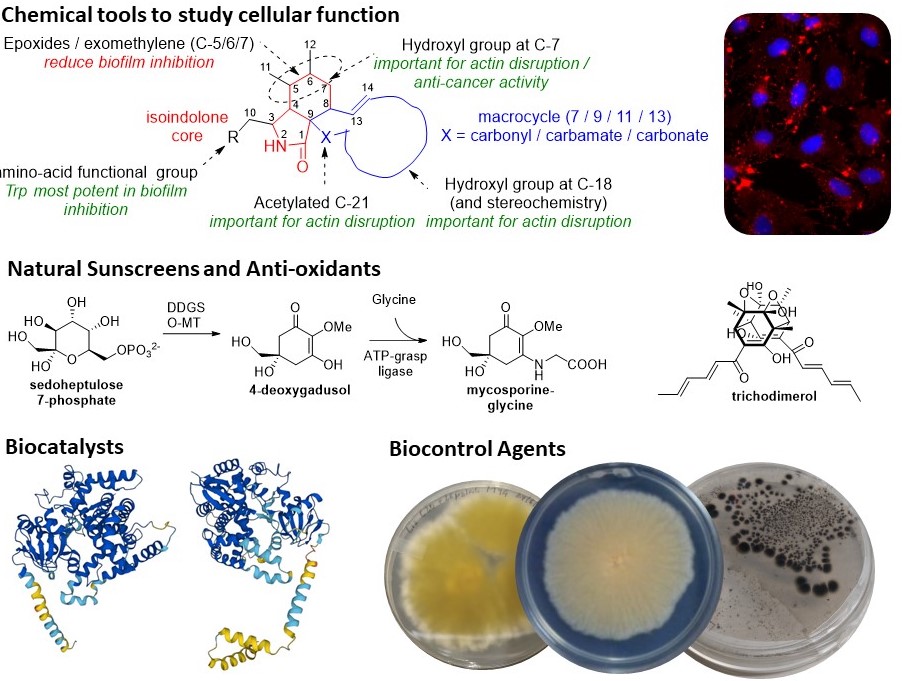
Research Overview

The Skellam group focuses on natural product biosynthetic pathway elucidation and engineering in microorganisms to generate and develop novel biocatalysts and bioactive molecules with potential use for the pharmaceutical, agrochemical, food, and cosmetic industries.
Current interests:
- Discovering and elucidating novel molecules, complex secondary metabolite pathways, and unusual biosynthetic enzymes using chemical and biological methods
- Developing heterologous expression systems to overcome low titers in addition to combinatorial biosynthesis to produce unnatural natural products
- Enzyme engineering to rapidly generate small libraries of bioactive small molecules with potential commercial applications
We are grateful to the following sponsors for funding our research and supporting our students:





